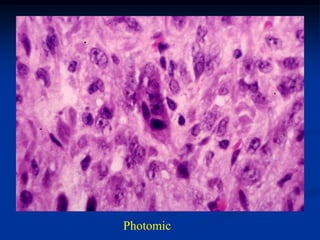
Photomic
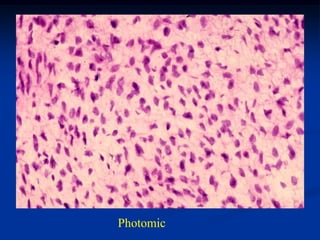
Photomic

This document describes several fibrous soft tissue tumors including desmoid tumors, aponeuratic fibroma, infantile fibromatosis, elastofibroma, and nodular fascitis. It provides details on the typical presentation, location, patient demographics, histological features, treatment and prognosis for each tumor type. Several case examples are also described with accompanying imaging findings and histopathology.